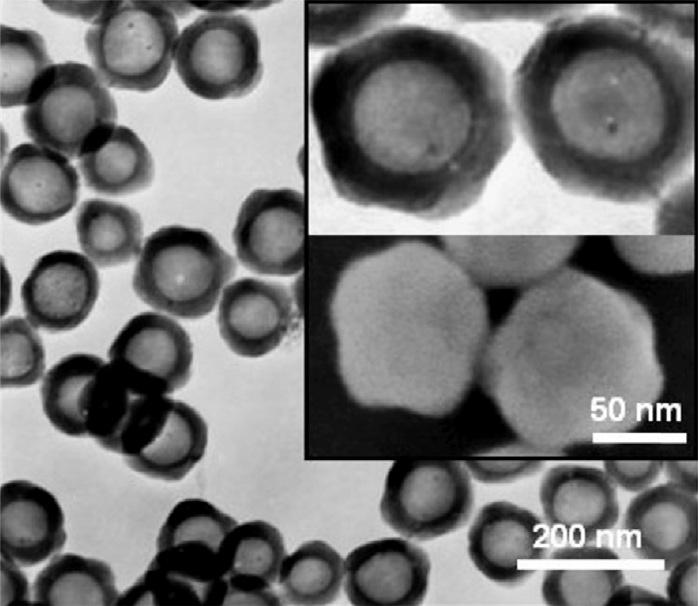

https://ebookmass.com/product/voids-in-materials-fromunavoidable-defects-to-designed-cellular-materials-2nd-
Instant digital products (PDF, ePub, MOBI) ready for you
Download now and discover formats that fit your needs...
Defects in Two-Dimensional Materials Rafik Addou
https://ebookmass.com/product/defects-in-two-dimensional-materialsrafik-addou/
ebookmass.com
Elements of Structures and Defects of Crystalline Materials Tsang-Tse Fang
https://ebookmass.com/product/elements-of-structures-and-defects-ofcrystalline-materials-tsang-tse-fang-2/
ebookmass.com
Optical Thin Films and Coatings 2e : From Materials to Applications. 2nd ed. Edition Flory
https://ebookmass.com/product/optical-thin-films-and-coatings-2e-frommaterials-to-applications-2nd-ed-edition-flory/
ebookmass.com
Networking All-in-One For Dummies 8th Edition Doug Lowe
https://ebookmass.com/product/networking-all-in-one-for-dummies-8thedition-doug-lowe/
ebookmass.com
The Moral of the Story: An Introduction to Ethics 8th Edition Nina Rosenstand
https://ebookmass.com/product/the-moral-of-the-story-an-introductionto-ethics-8th-edition-nina-rosenstand/
ebookmass.com
Eoin's Forbidden Mate: MM Wolf Shifter Romance (Ombra Pack Chronicles Book 4) Blake R. Wolfe
https://ebookmass.com/product/eoins-forbidden-mate-mm-wolf-shifterromance-ombra-pack-chronicles-book-4-blake-r-wolfe/
ebookmass.com
PHP: 3 books in 1 : PHP Basics for Beginners + PHP security and session management + Advanced PHP functions Andy Vickler
https://ebookmass.com/product/php-3-books-in-1-php-basics-forbeginners-php-security-and-session-management-advanced-php-functionsandy-vickler/ ebookmass.com
Fierce Cowboy Wolf Kait Ballenger
https://ebookmass.com/product/fierce-cowboy-wolf-kait-ballenger/
ebookmass.com
The Strategist's Handbook: Tools, Templates, and Best Practices Across the Strategy Process Timothy Galpin
https://ebookmass.com/product/the-strategists-handbook-toolstemplates-and-best-practices-across-the-strategy-process-timothygalpin/ ebookmass.com
https://ebookmass.com/product/the-learning-and-teaching-of-calculusideas-insights-and-activities-1st-edition-john-monaghan/
ebookmass.com
VoidsinMaterials GaryM.Gladysz
DepartmentofMaterialsScienceandEngineering, UniversityofAlabamaatBirmingham,Birmingham, AL,UnitedStates
KrishanK.Chawla
DepartmentofMaterialsScienceandEngineering, UniversityofAlabamaatBirmingham,Birmingham, AL,UnitedStates
Elsevier
Radarweg29,POBox211,1000AEAmsterdam,Netherlands
TheBoulevard,LangfordLane,Kidlington,OxfordOX51GB,UnitedKingdom 50HampshireStreet,5thFloor,Cambridge,MA02139,UnitedStates
Copyright©2021ElsevierB.V.Allrightsreserved.
Nopartofthispublicationmaybereproducedortransmittedinanyformorbyanymeans,electronicor mechanical,includingphotocopying,recording,oranyinformationstorageandretrievalsystem,without permissioninwritingfromthepublisher.Detailsonhowtoseekpermission,furtherinformationaboutthe Publisher’spermissionspoliciesandourarrangementswithorganizationssuchastheCopyrightClearance CenterandtheCopyrightLicensingAgency,canbefoundatourwebsite: www.elsevier.com/permissions.
ThisbookandtheindividualcontributionscontainedinitareprotectedundercopyrightbythePublisher (otherthanasmaybenotedherein).
Notices
Knowledgeandbestpracticeinthisfieldareconstantlychanging.Asnewresearchandexperiencebroaden ourunderstanding,changesinresearchmethods,professionalpractices,ormedicaltreatmentmaybecome necessary.
Practitionersandresearchersmustalwaysrelyontheirownexperienceandknowledgeinevaluatingand usinganyinformation,methods,compounds,orexperimentsdescribedherein.Inusingsuchinformationor methodstheyshouldbemindfuloftheirownsafetyandthesafetyofothers,includingpartiesforwhom theyhaveaprofessionalresponsibility.
Tothefullestextentofthelaw,neitherthePublishernortheauthors,contributors,oreditors,assumeany liabilityforanyinjuryand/ordamagetopersonsorpropertyasamatterofproductsliability,negligenceor otherwise,orfromanyuseoroperationofanymethods,products,instructions,orideascontainedinthe materialherein.
BritishLibraryCataloguing-in-PublicationData
AcataloguerecordforthisbookisavailablefromtheBritishLibrary
LibraryofCongressCataloging-in-PublicationData
AcatalogrecordforthisbookisavailablefromtheLibraryofCongress
ISBN:978-0-12-819282-5
ForInformationonallElsevierpublications
visitourwebsiteat https://www.elsevier.com/books-and-journals
Publisher: SusanDennis
AcquisitionsEditor: KostasKIMarinakis
EditorialProjectManager: SaraValentino
ProductionProjectManager: JoyChristelNeumarinHonestThangiah
CoverDesigner: AlanStudholme
TypesetbyMPSLimited,Chennai,India
Dedication GaryM.Gladyszwouldliketodedicatethistohisparents,EdwardandKathy;andhiswife anddaughtersApril,Amelia,andClairefortheirconstantencouragement!
KrishanK.Chawlawouldliketodedicatethistohiswife,Nivi,foralwaysbeingthere!
Abouttheauthorsxiii
Prefacetothefirsteditionxv
Prefacetothesecondeditionxvii
1.Introduction1
1.1Overview1
1.2Descriptions2
1.2.1Intrinsicandintentionalvoids2
1.2.2Closedandopencellporosity3
1.2.3Unreinforcedandreinforcedvoids5
1.2.4Porosityinnaturalandsyntheticmaterials7
1.2.5Stochastic,nonstochastic,andVoronoifoams9
1.2.6Materialversusdigitaldesignofvoids12
1.3Voidsthroughthelengthscale13 References15
2.Intrinsicvoidsincrystallinematerials:Idealmaterials andrealmaterials17
2.1Introduction17
2.2Crystallinematerials18
2.2.1Idealmaterialsandproperties18
2.2.2Defectsandrealproperties21
2.2.3Density25
2.3Mechanicalproperties25
2.3.1Modulus25
2.3.2Effectofvoidsonstrength28
2.3.3Griffiththeoryofbrittlefracture29
2.4Processingandservice-inducedvoids30
2.4.1Casting30
2.4.2Powderprocessingofmaterials31
2.4.3Voidsinsolders31
2.5Time-dependentproperties31
2.5.1Diffusionofvacanciesandvoids32
2.5.2Clusteringandfailure34
2.5.3Kirkendallvoidsincrystallinematerials35 References37
3.Intrinsicvoidsinpolymericnetworks41
3.1Polymerstructure41
3.2Freevolumeandthermomechanicalbehavior44
3.3Kinetictheoryofpolymerstrength46
3.4Thermalconductivity48
3.5Roleofvoidsinphysicalaginginpolymers49
3.6Measurementoffreevolume49 References50
4.Nanometerscaleporousstructures53
4.1Introduction53
4.2Nanotubes54
4.3Zeolites59
4.4Nanoporouspolymers61
4.5Nanoporousorganicnetworks64
4.5.1Covalentorganicframeworks65
4.5.2Covalenttriazineframeworks67
4.5.3Polymersofintrinsicmicroporosity(PIM)67
4.5.4Conjugatedmicroporouspolymers68
4.6Nanoporousnoblemetals71 References73
5.Hollowandporousstructuresutilizingthe Kirkendalleffect77
5.1Introduction77
5.2GeneralizedKirkendallmechanismforformation ofhollowparticles78
5.2.1Symmetrichollowparticles80
5.2.2Asymmetrichollowparticles81
5.3Tubes82
5.4Porousandhollowstructures85 References91
6.Techniquesforintroducingintentional voidsintomaterials95
6.1Introduction95
6.2Commonalitiesoffoamformationprocesses96
6.3Introductionofagas97
6.3.1Mixing97
6.3.2Physicalblowingagent99
6.3.3Chemicalblowingagent101
6.4Templatingorsacrificialporeformer105
6.4.1Aerogels106
6.5Bondingtogetherofspheres,fibers,powders,orparticles107
6.6Additivemanufacturingofcellularstructures109
6.7Mechanicalstretching123
6.8Exploitingchemicallyselectiveweaknessinsolids124
6.9Hierarchicaldesignwithvoids129 References132 Furtherreading137
7.Techniquesofintroducingintentionalvoidsinto particlesandfibers139
7.1Introduction139
7.2Hollowandporousparticles139
7.2.1Introduction139
7.2.2Processingofporousparticles140
7.2.3Hollowparticles143
7.2.4Hollow,porousparticles147
7.2.5Porousandhollowmacrometerscaleparticles150
7.3Hollowandporousfibers154
7.3.1Carbonnanotubes158
7.4Nonsphericalhollowparticles160 References162
8.Voidcharacterizationtechniques167
8.1Introduction167
8.2Microscopy167
8.2.1Opticalmicroscopy167
8.2.2Electronmicroscopy168
8.3Positronannihilationlifetimespectroscopy(PALS)172
8.4Three-dimensionalimaging174
8.5Gasadsorption178
8.6Chromatographicporosimetry180
8.6.1Introduction180
8.6.2Inversegaschromatography(IGC)181
8.6.3Inversesizeexclusionchromatography183 References186
9.Characteristicsandpropertiesofporousmaterials189
9.1Introduction189
9.2Generalcharacterization190
9.2.1Cellsize190
9.2.2Openversusclosedcell191
9.2.3Reinforcedversusunreinforcedvoids193
9.2.4Density195
9.2.5Relativedensity196
9.2.6Energyabsorption197
9.2.7Cellsizedistributionandregularity199
9.3Conventionalfoams202
9.3.1Stress strainbehaviorincompression202
9.3.2Elasticconstants203
9.3.3Dielectricconstant206
9.4Syntacticfoams208
9.4.1Growthandperformance208
9.4.2Compressivestress strainrelationship210
9.5Thermalproperties212
9.6Finiteelementanalysis(FEA)217
9.7Geopolymerfoams220
9.8Metallicfoams222 References226 10.Applications231 10.1Introduction231 10.2Syntacticfoams233
10.2.1Deep-seabuoyancy233
10.2.2Hollowcompositemacrospheresandcomposite syntacticfoams238
10.2.3Deep-seathermalinsulation239
10.2.4Syntacticfoamsandexplosiveformulations240
10.2.5Otherapplication242 10.3Aerospace243
10.3.1Carbonnanotubes(CNT)243
10.3.2Honeycombs245
10.3.3Thermalprotectionsystemsandheatshields246
10.3.4Silicaaerogelforacometdustcollector249
10.3.5Thermalbarriercoatings(TBCs)254
10.4Energy257
10.4.1Lithium-ionbattery257
10.4.2Electrochemicalenergystoragewithporousmetals259
10.4.3Guest hostcomplexes261
10.4.4Solarpower263 10.5Titaniaandphotocatalysis263 10.6Biomaterialsandhealthcare265
10.6.1Introduction265
10.6.2Biomaterialsscaffold267
10.6.3Nerveregeneration268
10.6.4Drugdelivery272
10.7Mengersponges272 References275
Glossary281
Authorindex285 Subjectindex297
Abouttheauthors GaryGladysz isanadjunctassociateprofessorofmaterials scienceandengineeringattheUniversityofAlabamaat Birmingham,UnitedStatesandfounderatX-Link3Dat Youngstown,OH,UnitedStates.HereceivedhisPhDfromthe NewMexicoInstituteofMiningandTechnology,wherehe participatedintheNATOCollaborativeProgramwiththe GermanAerospaceInstitute(DLR).SincereceivinghisPhD, hehasledresearcheffortsinuniversity,government,and industrialsettings.Hehasextensiveresearchexperience designingandcharacterizingthermosetcompositematerialsfor3Dprinting,fibrous composites,ceramiccomposites,polymers,compositefoams,andthinfilms.Asa technicalstaffmemberatLosAlamosNationalLaboratory(LANL),hewastechnical leadforrigidcompositesandthermosetmaterials.In2005hewasawardedthe LANLDistinguishedPerformanceGroupAwardforhisworkleadingmaterialsdevelopmentontheReliableReplacementWarheadFeasibilityProject.Additionally,while theUSArmy,hedevelopedcompositematerialsandtestprotocolsforballistichead protection.HehasservedonfundingreviewboardsforLANL,NationalScience Foundation,ACS,andtheLindberghFoundation.Hehasbeenguesteditoronmany issuesofleadingmaterialssciencejournals,including JournalofMaterialsScience and MaterialsScience&Engineering.Hehasorganizedmanyinternationalconferences/symposiaonsyntacticfoams,compositematerials,andinnovativematerials foradditivemanufacturing.HestartedandchairstheECIinternationalconference seriesonSyntacticandCompositesFoams.HecurrentlylivesinBoston, Massachusetts,UnitedStates.
Professor KrishanChawla obtainedhisBSfromBanaras HinduUniversityandhisMSandPhDdegreesfromthe UniversityofIllinois at Urbana-Champaign,UnitedStates.He hastaughtand/ordoneresearchat(inalphabeticalorder) ArizonaStateUniversity,Tempe,AZ(UnitedStates);Ecole PolytechniqueFederaledeLausanne(Switzerland);Federal InstituteforMaterialsResearchandTesting(BAM),Berlin (Germany);GermanAerospaceResearchInstitute(DLR), Cologne(Germany);InstitutoMilitardeEngenharia(Brazil); LavalUniversity(Canada);LosAlamosNationalLab(United States);NewMexicoTech(UnitedStates);NorthwesternUniversity(UnitedStates); UniversityofAlabamaatBirmingham(UnitedStates);andUniversityofIllinois at Urbana-Champaign(UnitedStates).
Hehaspublishedextensivelyintheareasofprocessing,microstructure,and mechanicalbehaviorofmaterials,ingeneral,andcompositematerialsandfibers,in particular.Besidesbeingamemberofvariousprofessionalsocieties,heisEditorof InternationalMaterialsReview (publishedjointlybyASMInternational,United StatesandtheInstituteofMaterials,London)andamemberoftheEditorialBoard ofvariousjournals.During1989-1990,heservedasaProgramDirectorformetals andceramicsintheDivisionofMaterialsResearch,NationalScienceFoundation, Washington,DC,UnitedStates.Heservesasaconsultanttotheindustry,US nationallaboratories,andvariousUSfederalgovernmentagencies.In1992hewas therecipientofthe EshbachSocietyDistinguishedVisitingScholarAward from NorthwesternUniversity.DuringtheperiodofJune,1994throughJune,1995he heldthe USDept.ofEnergyFacultyFellowship atOakRidgeNationalLab.In1996 hewasgiventhe DistinguishedResearcherAward bytheNewMexicoTech.In1997 hewasmadea FellowofASMinternational.In2000hewasawardedthe DistinguishedAlumnus awardbyBanarasHinduUniversity.Hereceivedthe President’sAwardforExcellenceinTeaching,UniversityofAlabamaatBirmingham in2006.In2018hewasawardedthe AlbertNelsonMarquisLifetimeAchievement Award.
Prefacetothefirstedition Thetitleofthisbook, VoidsinMaterials:FromUnavoidableDefectstoDesignedCellular Materialssayseverything.Allmaterialshavevoidsatsomescale.Sometimesthevoidsare ignored,sometimestheyaretakenintoaccount,andothertimestheyarethefocalpointofthe research.Inthisbook,however,wetakeduenoticeofalloftheseoccurrencesofvoids,whether designedorunavoidabledefects,wedefinethesevoids(oremptyspacesinmaterials),categorizethem,characterizethem,anddescribetheeffecttheyhaveonmaterialproperties.
Afteranintroductorychapter,wedevoteachaptereachonintrinsicvoidsincrystalline materials(suchasmetalsandceramics)andinpolymers.Weexplainthedifferences betweenidealandrealmaterialsasrootedinthevoidsanddefects.Wediscusstheorigins, diffusion,andcoalescenceofvoids/defectsandtherelationtophenomenasuchascreep, physicalaging,diffusion,glasstransitiontemperature,thermalexpansion,howmaterial propertieschangewithsize,distribution,andamountofvoids,andtheimplicationsthat voidshaveonproductdesign.Thisisfollowedbyachapteronintentionalvoidsinmaterials. Oftentimes,themethodsandthevocabularyrelatedtofoamsarematerial-specific.Similar methodscanbecalledbydifferentnameswhenworkingwithametalorceramic.Wepoint outthecommonalitiesinthewaythevoidsareintroducedindifferentmaterials,highlight thesimilarities,andpointoutthedifferenttermsusedtodescribethem.Inadditiontoa chapteronintentionalvoidsinbulkmaterials,wedevoteachapterontheintroductionof voidsintodispersedphasessuchasparticlesandfibers.Structuressuchasnanotubes,hollowandporousspheres,membranes,andnonsphericalparticlesaretechnologicallyimportantinfieldsasdiverseascatalysis,biomaterials,ablation,compositematerials,and pharmaceuticals/medicine.Achapterisdevotedtocellularmaterialsorfoams,whereinwe highlightthecommonalitiesinmaterialpropertiesofvoidsinpolymers,metals,andceramics.Finallybroadapplicationsofsuchcellularmaterialsaredescribedalongwithtechniquesusedtocharacterizevoids.
Throughoutthebookwehavetakentheapproachofhighlightingthephysicsandchemistryofthesubjectmatterunderconsiderationwhileminimizingthemathematicalpart. Extensiveuseismadeoflinedrawingsandmicrographstobringhometothereaderthe importanceofvoidsasunavoidablestructuraldefectsaswellasvoidsbeinganelementof designtoobtainthedesiredpropertiesinamaterial.Theintendedaudienceforthisbook arestudents,researchers,practicingengineersinthefieldsofmaterialsscienceandengineering,physics,chemistry,andmechanicalengineering.
Finally,wewouldliketoacknowledgeourcolleagueswithoutwhosehelpwewouldnot havebeenabletodothisproject.GaryM.GladyszwouldliketothankA.Boccaccini,K. Carlisle,W.Congdon,L.Dai,S.Emets,N.Godfrey,M.Koopman,M.Lewis,J.Lula,U.Mann, G.McEachen,D.Mendoza,B.Perry,W.Ricci,S.Rutherford,C.Sandoval,andV.Shabde.
KrishanK.ChawlawouldliketothankA.Boccaccini,N.Chawla,K.Carlisle,M.Koopman, M.Lewis,andA.Mortensen.ThanksareduetoKanikaChawlaandA.Woodmanforhelp withthefigures.
GaryM.Gladysz1,2,KrishanK.Chawla1 1 DEPARTMENTOFMATERIALSSCIENCEANDENGINEERING,UNIVERSITYOFALABAMA ATBIRMINGHAM,BIRMINGHAM,AL,UNITEDSTATES 2 X-LINK3D,YOUNGSTOWN, OH,UNITEDSTATES
Prefacetothesecondedition Rightfromthestageofconceptionofthisbook, VoidsinMaterials:FromUnavoidable DefectstoDesignedCellularMaterials,ourgoalwastocreateabookfocusingonvoids,independentofthematerialcontainingthevoids.Webelievethisiswhatdistinguishesourbook fromotherbooksonfoamsordefects,etc.Sincethefirsteditionin2014therehasbeensignificantprogressinthisfield.Theexpansionisdrivenbythemaximizingfunctionalitywhile minimizingmassofthepartandthetimetoneededtomakethepart.Wehaveexpandedon thesethemesinthesecondedition,addingnewcontentthatincludesthelatesttopicsand applicationsofcuttingedgeresearchanddevelopment.Wehopethatthestudents,scientists, researchers,andengineerswillfindthenewcontentandorganizationofthebookcompellingandinaccordwiththeoverallconcept.Anotherpositiveaspectofthisbookisthewealth ofreferencesandfurtherreadingsuggestionsthatweprovideattheendofeachchapter. Thiswilldirectreaderswhowishtoexploretopicsinmoredepthtotherelevantliterature.
Thecoverdesignofthiseditionvisuallyencapsulatesmanyofthekeyconceptsdiscussed. Thoughthereisnoscalemarker,onecanimmediatelyrecognizethebottomgraphicasa carbonnanotube.Thatfactthatthehollowportionisanintentionalvoidonthesinglenanometerlengthscaleisatestamenttotheprecisionwenowhaveonthedesignofmaterials. Evenonasmallerlengthscaleisthearrangementoftheatomscreatingthegrapheneshell ofthecarbonnanotubecreatingahoneycomblikepatternwithnonstochasticintrinsicvoids. Thetopimageshowsablownstochasticfoamwithagradientcellstructuremadeof micrometerscaleintentionalvoids.Incontrast,theinterfaceregionscontainintrinsicvoids; intrinsicsincethelevelofcontrolovertheprocessmakethesedefectsunintentionalyetinevitable.Thespanoflengthscaleofvoidsjustdiscussed,subnanometer,nanometer,and micrometersuggestthatabilityforhierarchicaldesignofporosity.
Atopicthathasthatbeenexpandedwithnewcontentinmultiplechaptersisadditive manufacturing(AM)or3Dprinting.Thisreflectstherapid,worldwideexpansionofAMin researchanddevelopment,manufacturing,andapplications.Wediscussthesevendistinct technologieswithinAMandhighlightinterestingporousstructuresforeach.Wediscussthe newconceptofthedigitaldesignofvoidsandtheroleithasinmasscustomization;tailoring adidasshoesandbiomaterialscaffoldstosuitanindividual ’sneed.Digitaldesignofporosity hasmadeitpossibletotailorregularity(R)fromcompletelystochasticandrandom(R 5 0) tononstochasticandordered(R 5 1)andeverythinginbetween.Wediscussregularityasit relatestoVoronoistructures,designingandtailoringvoidswithinastructuretoachievecertainfunctionalities.Needlesstosay,thisisonlypossiblewithAM.
InthefirsteditionwehadasectionortwodiscussingtheKirkendalleffect.TheKirkendall effectwheninitiallyidentifiedinthe1940swasthoughtofasdetrimentalinmetals.However,in theearly2000s,methodsandproceduresweredevelopedtoconstructivelyusethis “detrimental”
effecttodesignandcreatehollowstructures.Sincebecomingaprocessforcreatingintentional porosity,theresearchhasdramaticallyincreased.WenowdevoteanentireChapter5,Hollow andporousstructuresutilizing theKirkendalleffect,tocoverthetopicindetail.Wecoverhollow particleandtubeformationonthenanometerandmicrometerscaleandwellasporousparticles andfibers.Wediscuss symmetric and asymmetric Kirkendallmechanismsforcreatinghollowparticleandfibersandexplaintheunderlyingphenomenathatleadtoeach.
AnotherentirelynewchapterisChapter4,Nanometer-scaleporousstructures. Nanotechnologyhasalreadymadeitswayintoourdailylivesintheoptics,chemicalfiltration,desalinization,andsensorstonameafew.Wediscussmanytypesofcuttingedge researchonnanocellularfoams,nanoporousnoblemetals,zeolitesaswellasthevarious nanoporousorganicnetworks(covalentorganicframeworks,covalenttriazineframeworks, polymersofintrinsicmicroporosity,andconjugatedmicroporouspolymers).
Wehaveexpandedthe Applications chaptertoincludeawidevarietyofnewapplications fromusingaerogeltocollectcometdust,electrochemicalenergystorage,tothermalbarrier coatingofjetengines.
Finally,wewouldliketoacknowledgeourcolleagueswhosecontributionstothissecond editionhavebeeninvaluable.GaryM.GladyszwouldliketothankA.Boccaccini,K.Carlisle, A.Campanella,J.J.Castellón,W.Congdon,M.Gromacki,N.Gupta,C.Hershey,M. Koopman,M.Lewis,J.Lindahl,O.Manoukian,D.Mendoza,V.Mishra,B.Pillay,D.Schmidt, C.Sandoval,andK.Shah.KrishanK.ChawlawouldliketothankA.Boccaccini,K.Carlisle,N. Chawla,M.Koopman,M.Lewis,andA.Mortensen.ThanksareduetoKanikaChawlaandM. Armstrongforhelpwithfigures.
GaryM.Gladysz1,2,KrishanK.Chawla1
1 DEPARTMENTOFMATERIALSSCIENCEANDENGINEERING,UNIVERSITYOFALABAMA ATBIRMINGHAM,BIRMINGHAM,AL,UNITEDSTATES 2 X-LINK3D,YOUNGSTOWN,OH, UNITEDSTATES September1,2020
Introduction 1.1Overview Sowhywriteabookjustonvoidsinmaterialsasthetopic?Theanswerissimpleand twofold first,thejuxtapositionof “emptyspace” adjacenttosolidmaterialseemed,to us,aninterestingdichotomy.Second,dependingonone’sperspectiveordesiredoutcome,voidscanlimitorenhancetheperformanceofmaterials.Isthetargetaconsolidatedmaterialorafoam?Ifthetargetisafoam,howdomaterialpropertieschange withthetypeandamountofvoids;opencellversusclosedcell,themeansize,size distribution,volumefractionofvoids,etc.?Ifthetargetisaconsolidatedmaterial, someimportantquestionsmightbehowdopropertieschangewiththevolumepercent,location,geometry,andsizeofunwantedvoids?Anotherinterestingquestionis howdothosevoids,onthesubnanometerandnanometerscales,whicharetypically notcharacterizedbyfoamresearchers,playintothefinalproperties.
Voidsarealsoveryimportanttounderstandfromapracticalengineeringstandpoint.Eveninthemosthighlyengineereddensifiedmaterials,defects,suchasvoids, willlimitthedesignofrealstructures.Soalongwiththetheoreticalexplorationof voidsinmaterials,inthisbook,weprovideexamplesofreal-worldapplications whereinvoidsareprevalentinstructuresandaffecttheirproperties.
Inthisbookweexploresuchdichotomies;solidversusemptyanddesiredversus undesiredaspectsofvoidsinmaterials.Furthermore,wewouldliketoshedlighton a “middleground” ofthesmartuseofvoidstohelpintheoptimizationofperformanceofapart.Bymiddlegroundwemeananeutrallookattheimpactvoidshave onmaterial/partsanduseofvoidsasadesignparameterforoptimizingperformance inmultifunctionalmaterials.Thereismuchpublishedworkavailableonfoams (Gibson&Ashby,1997;Shutov,2004).Evenmorenumerousarethosethatprovide apassingmentionofvoidswhentheyareincidental/unwantedduringthefabricationofnominallydensematerials.Thisbook,however,isnotjustaboutfoamsor residualporosityinmaterials,importantthoughthesecontributionsare;insteadit focusesonthe void itself.Thefactisthatallmaterialshavevoids,thatis,theyare pervasiveinallmaterialsatsomelengthscale.So,inadditiontovoidsinfoams,this bookbringsininformationfromanumberofdifferentfieldsofstudysuchasmaterialscienceandengineering,physicsandchemistryofmaterials,andmechanicsof materials.Thisbooktreatsallofthese “different” typesofvoidsequallyand
highlightstheircommonalitiesinallaspects fromprocessing,formation,and characterizationtotheresultingmaterialproperties.
Forthepurposeofthisbook,avoidhastwoessentialproperties,itmustbe(1)a volumemeasuredincubeofsomeunitoflengthand(2)occupiedbyavacuumor gas(i.e.,solid/liquidmaterialsareabsent).Ingeneral,thereisnosizeorshape requirementonavoid;soitrangesfromsubnanometerstomillimeters,sometimes evenlarger,inequivalentdiameter.Weshouldmakeitclearthatvoidsinaliquid andgaseousmediumwillnotbecoveredinthisbook.Wedevotetherestofthis chaptertoageneraldiscussiononvoids.
1.2Descriptions 1.2.1Intrinsicandintentionalvoids
Intrinsicvoids appearinmaterialsbecauseofinherentstructure,naturalprocesses, processinglimitations,and/oraginginserviceenvironments.Atsomelengthscale,all realmaterialshaveintrinsicvoids.Attheatomiclevel,ifweexaminetheBohratomic model,weseethatmostofthevolumeoccupiedbyanatomisemptyspace.Wewill notbegoingintodetailsoftheBohrmodelinthisbook,butitisimportanttomention.Ageneralchemistrytextissufficienttoreviewthegeneralstructureofatoms.
Whenvoidsarethoughtofasdefects,theyareviewedashavingadetrimentaleffect onmaterialproperties.However,sometimes defectscanbebeneficialandessentialto specificmaterialbehavior,suchascolorcentersandsemiconductingproperties.The intrinsicvoidsgenerallyrangefrom10 15 to10 3 m;examplesincludeatomicvacancies,freevolume,latticeholes,andprocessinducedporosity.
Intentionalvoids areincorporatedbydesignintoasolidmaterial.Suchmaterialsare usually,butnotalways,referredtoasfoams.Thisisespeciallytruewhenthevoidsareon amicrometerscale.Intheearly21stcentury,technologyhasevolvedtoanextentthatwe cancontrolvoidsinthesinglenanometersizerange.Materialswithintentionalvoidscan beclassifiedinmanyways.Someimportantexamplesare single-phasefoams, composite and syntacticfoams (Gladysz&Chawla,2002).Therearemanywaystointroduceanintentionalvoidintoamaterial,themethodofintroducingthesevoidsishighlydependenton thetypeofmaterialtheyareintroducedintoaswellasthedesiredpropertiesneededin thefinishedmaterial.Detailsofthese processeswillbecoveredinChapters5 7.
Whenwediscussintentionalvoidsinamaterial,itisimportanttorememberthat theintrinsicvoidsontheatomicand/ornanometerlengthscalemaystillbepresent. Fig.1 1 isanexampleofanintrinsicvoidinthewallofahollow(intentionalvoid) glassmicrospheresformedduringthespraydryingformationprocess.Thehollow coreofthesphereisinthemicrometerrangeandtheunintentionalvoidsinthe
FIGURE1–1 Ahollowglasssphereillustratingnanometer-scaleintrinsicvoidscausedbyprocessing andtheintentionalvoid,thehollowcoreofthesphere.
FIGURE1–2 Anidealizedstructureofacellconsistingofstrutsandfaces.
shellareinnanometer/submicrometerrange.Thisintrinsicvoidweakenstheshell ofthesphereandcanbethecauseoffailureduringservice.
Independentofthematerial,voidscanbecategorizedas reinforced or unreinforced and open or closedcell.Wewilldiscusstheconceptsofopencellversusclosed cellandreinforcedversusunreinforcedin Sections1.2.2and1.2.3,respectively.
1.2.2Closedandopencellporosity Whetherdiscussingcellsinfoamorjustgeneralporosity,theyaresimplyvoidsdispersed inasolidphase.Cellsaremadeupofstrutsandfaces,asshownschematicallyin Fig.1 2,thatsurroundthevoidspace.Inaclosedcell,thefaceofthecellwallconsistsof acontinuoussolidphase.Inanopencellmaterial,apartofthatwallismissing.
Inaflexibleopencellfoam,see Fig.1 3A and B,gascanfreelyflowinoroutof thecellswhenthestructureisextendedorcompressed.Becausethecellfacesare
FIGURE1–3 Examplesofthestructure:(A)lowmagnificationand(B)highermagnificationofopen cellreticulatedfoam(C)aclosedcellsiliconefoam. Source:Lepage,G.,Albernaz,F.O.,Perrier,G.,& Merlin,G.(2012).Characterizationofamicrobialfuelcellwithreticulatedcarbonfoamelectrodes. BioresourceTechnology,124,199 207.
discontinuous,materialscontainingopencellstypicallyhavealowermodulusand strengththanthosecontainingclosedcells.Thereticulated(meaningweblike)foam in Fig.1 3 isanextremeexampleofanopencellfoamasitiscomposedentirelyof strutswithoutfaces.Thismaterialisacandidateforanelectrodeinmicrobialfuel cell(Lepage,Albernaz,Perrier,&Merlin,2012).Therearesomegeneralconditions neededforamaterialtobeopencell.Accordingto Shutov(2004),thefollowingtwo criteriamustbemetforapredominantlyopencellstructure:
• Eachpolygonalcellmusthaveatleasttwodiscontinuousorbrokenfaces.
• Anoverwhelmingmajorityofthecellstrutsmustbesharedbyatleastthreecells. Fromtheabovecriteria,itisclearthatthephysicalstructureofopencellfoamsand resultingpropertiescanvarywidely.Wediscussthesestructure propertyrelationshipsin moredetailinChapter9,CharacteristicsandpropertiesofPorousMaterials.Ingeneral, opencellfoamsexhibitgoodabsorptioncapacityforwaterandgoodacousticdamping properties(Zhang,Li,Hu,Zhu,&Huang,2012)comparedtoclosedcellfoams.
Inclosedcellfoams(Fig.1 3C)thefacesarecontinuous,whichleavesgasesinside individualcellsisolatedfromthesurrounding cells.Becausethefacesareintact,closed cellfoamstypicallyhavehigherstrengthandmodulusthanopencellfoams.Inaddition tosuperiormechanicalproperties,theyareusedextensivelyfortheirinsulatingproperties(Jelle,2011),becausetheairtrappedinthecellsreducethermalconductivity.
1.2.3Unreinforcedandreinforcedvoids Unreinforcedvoids arepresentinmostmaterialsthatwedealwithonaday-to-day basis.Conventional,single-phasefoamsarethemostrecognizablematerialsthat haveunreinforcedvoids.Acommonexampleofasingle-phasefoamcontainingan unreinforcedvoidphaseisthepolyurethanefoamused,forexample,forcushioning infurnitureandexpandedpolystyrene(PS)usedforinsulation.Examplesofunreinforcedvoidsareshownin Fig.1 3A C.
Foamscontainingunreinforcedvoids,aswementionedabove,makeaverylarge classofmaterialsandfindwideapplications.Therearemanybooksandjournals dedicatedtothebehaviorofsuchfoams,sowhatwepresentinthisbookonthis topicwillbeofageneralnatureandthereaderwillbedirectedtothesuggested readinglistedformoredetails.
Reinforcedvoids aremostlyencounteredinaclassofmaterialscalled syntactic foams or compositefoams (Gladysz&Chawla,2002).Theyoccurwhenoneofthe reinforcingphasesisholloworporous.Examplesofhollowreinforcingphasesare glassmicroballoonsandhollowfibers,suchascarbonnanotubes.
Theneedtodistinguishbetweenreinforcedandunreinforcedvoidsbecameevidentwiththedevelopmentofsyntacticfoamsinthe1960sand1970s.Thefirstwidespreaduseofsyntacticfoamswasforuseindeep-seabuoyancyandinsulation applications.Voidsareintroducedinasyntacticfoambybondingtogetherofahollowmaterial,typicallyintheformofmicroballoons,withabinderphase.Thehollow particleormicroballoonisthereinforcedvoidphase;theshelliscommonlymadeof glass;however,theshellcanbemadeofphenolic,carbon,ceramic,ormetalalso. Thebinderphasecanbeapolymer,metal,orceramic.
Syntacticfoamscanbefurthercategorizedastwo-orthree-phasesyntacticfoams. Athree-phasesyntacticfoamismadefrommicroballoons,abinderphase,andinterstitialvoids.Thisinterstitialvoidisanunreinforcedvoid;itcanbeeitheropenor closedcellandcanbeengineeredintothesyntacticmaterialinordertominimize density.Althoughnotreferredtoassuch,hollowfibers,suchasnanotubeswhen embeddedinamatrix,canbeviewedasreinforcedvoidandasyntacticfoam. Syntacticfoamsareusedwherehighspecificstrengthandmodulusmaterialsare needed.
FIGURE1–4 (A)Aschematicofathree-phasesyntacticfoamwhereinterstitialvoidisengineeredinto thematerialand(B)atwo-phasesyntacticfoamwherethereissufficientbindertofilltheinterstices. (C)Scanningelectronmicrographofacrosssectionofasyntacticfoam,illustratingunreinforced (matrixnanoporosity)andreinforced(glassmicroballoon)voidontwodifferentlengthscales, micrometerandnanometer.
Fig.1 4 comparestwo-andthree-phasesyntactic foams.Three-phasesyntacticfoams (Fig.1 4A)aredesignedsuchthatthemicroballoonandbinderphasevolumefractionis lessthanone;theremainderbeingtheunreinforced,interstitialvoid.Two-phasesyntactic foams(Fig.1 4B)aredesignedsothatthevolumefractionsofthebinderphaseand microballoonsadduptounity,thatis,thereisenoughbindertofilltheinterstices betweenthemicroballoons.Typically,thedimensionsoftheunreinforcedvoidsinasyntacticfoamareonamicrometerscale. Fig.1 4C showsthemicrostructureofathreephasesyntacticfoam,madeofglassmicroballoonsandporouspolymerbinder.
Thereareseveralexamplesofhollowmicrospheres(micrometerscaleindiameter)availablecommercially.Glass,phenolic,andceramicparticlesarethemostcommonones.Inlargescalemanufacturing,hollowparticleformationprocessesrelyon a blowingagent.Theinternalgasexpandstheskinofthehollowparticlewhichthen coolsandhardensintoaparticlewithacentralvoid.
FIGURE1–5 Silicananospheresdemonstratethecontrolofvoidsdownto50nmrange.Theinsetsshow highermagnificationofthenanospheres(SEMandTEM). Source:Huang,S.,Yu,X.,Dong,Y.,Li,L.,& Guo,X.(2012).Sphericalpolyelectrolytebrushes:IdealtemplatesforpreparingpH-sensitivecoreshell andhollowsilicananoparticles.ColloidsandSurfacesA:PhysicochemicalandEngineeringAspects, 415,22 30.
Itispossibletomakereinforcedvoidsonnanometer,micrometer,andmacrometer scales.Onananometerscale,hollowsphericalshellshavebeenmadebytemplating nanoparticlesonasacrificialcorematerial(Minami,Kobayashi,&Okubo,2005)orbubble (Hadiko,Han,Fuji,&Takahashi,2005).Anothertechniquethatcanbeusedisplasma polymerization(Cao&Matsoukas,2004). Fig.1 4C showsathree-phasesyntacticfoam; thebinderphasehavingnanometer-scaleunreinforcedporosity,withaglassmicroballoon reinforcedvoid. Fig.1 5 showsanexampleofhollowparticlefabricatedatthesubmicrometerrangeandnanometerrange(Huang,Yu,Dong,Li,&Guo,2012).Thesearesilica hollowparticlesproducedviathetemplatingmethod.ThesacrificialcorewasPSwith polyacrylicacid(PAA)attachedtothesurface.ThefunctionalityofthePAAwastodirect andcontrolthecoatingofsilica.ThePS/PAA corewasdissolvedusingchloroformleaving behindahollowparticle.
1.2.4Porosityinnaturalandsyntheticmaterials Therearemanynaturallyoccurringmaterialsthatareusedtoday,forexample,graniteandmarblecountertopsandlumberandstoneusedinconstruction.Infact,from asupplychainandrawmaterialsstandpointallofouradvancedmaterialscome fromnature.Asthestoneandlumberindustryillustrates, “[I]fitisnotgrown,thenit ismined.” Forexample,polymerscanbemadefromfossilfuelorplant-basedfeed stocks.Naturalmaterialsarethebuildingblocksofallengineeredmaterials.There arenumerousexamplesofporousmaterialsthatarefoundinnature.Sometimes thesematerialsareminedanddirectlyusedasfunctionalmaterials,whereasatother timesanaturalmaterialisstudied,anditsmicrostructureisreplicatedinthe
laboratory.Thereplicationinthelabisgenerallyanattempttonarrowthe inevitablevariabilityseeninanaturalmaterial.Wedothisbyimplementingprocess andrawmaterialcontrolstoreducevariability;thuscreatinganengineeredproduct.
WewouldliketouseCastelladeSanMarcus,locatedinFlorida,UnitedStatesas anexample.Itsconstructiondatesbackto1672,centuriesbeforetheemergenceof modernmaterialsscienceandengineering.Since1672thestructurehassurvivedwars andhurricanes,atleastpartly,becauseofthedurabilityofthewalls(Fig.1 6).The porouswallsofthisstructureareknownfortheabilitytoabsorbtheenergyofprojectiles,likebulletsandcannonballs,withoutlargecrackemanatingfromthepointof impactthatwouldleadtocatastrophicfailure(Subhash,Jannotti,&Subhash,2016). Interestingly,becauseofthematerialsselectionandconstructionofthewalls,thisfort wasnevertakenbyforce.Thenaturalmaterialofwallconstructionisaporousrock formationcallcoquina.Theabilitytoabsorbtheenergyofprojectileshastodowith theuniquemicrostructure).Coquinaisclassifiedasasedimentaryrock,thatis,itis madeupoffragmentsofotherpreexistingrocks.Itisacompositeoffragmented
FIGURE1–6 AphotographoftheCastelladeSanMarcuslocatedinSt.Augustine,FL,UnitedStates. Theoriginalconstructionstartedin1672.Thechoiceofmaterialfortheexteriorfacingwallsis coquina,aporoussedimentaryrockwithanotedabilitytoabsorbtheenergyfrombulletsand cannonballsofthattimewithoutexperiencingbrittlefracture.
marineshells,fossilsandcoral,limestone,sand,mineralsandclay,withsignificant voidspacebetweenthesesolidcomponents.Thevoidsarelocatedattheinterstitial positionsbetweentheshellfragments.Followingisasummaryofthenaturalprocess thatresultsincoquinaandsedimentaryrocks,ingeneral:
• Weatheringofexistingrock,marineshells,
• transportationoftheweatheredshells,
• depositionofshellsinlayers,
• compaction,and
• cementation.
Thelasttwoitemsintheabovelistarecalled lithification,meaning “convertinto solidrock.” Sincethereareinterstitialvoidspresent,thistypeofrockisconsidered partiallylithified.Thisnaturalprocessofintroducingvoidsinsedimentaryrockhas analogousprocessingstepsinengineeredsyntheticmaterials.However,tomakecomparableengineeredmaterial,thetimescaleneedstobesignificantlycompressed.We discusstheseprocessesindetailinChapter6,TechniquesforIntroducingVoidsinto BulkMaterials,TechniquesofIntroducingIntentionalVoidsintoParticlesandFibers. Asyntheticmaterialthathasmicrostructuralandprocessingsimilaritiestocoquina isfritmaterial;frithasanetworkofparticlesconnectedatcontactpointswithinterstitialporosity.Forexample, ChoandKim(2016) usedzincaluminumborosilicateglass ceramictoinvestigatethedependenceofparticlesizeonthedensificationand mechanicalbehaviorofthefinalfritmaterial.Theprocesshassimilaritieswiththe partiallylithifiedsedimentaryrockformation,theprocessdonebyChoandKimisas follows,withtheanalogoussedimentaryrockformationstepsgiveninparentheses:
• Jetmillandballmilltocrushglassintodesiredparticlesize(Weathering).
• Sedimentationtosize-separateparticles(Transportation/deposition).
• Centrifugetopacktheparticles(Compaction).
• Hightemperaturesintering(Cementation).
Fig.1 7 isanSEMmicrographofthematerialsmadeupofdifferentparticlesizes afterthecentrifugestep.Atthispointtheloosepowderisconsolidatedbutthereis nobondingbetweenthediscreteparticles.Thesematerialswereprocessedfurther at900 Ctofusetheparticlestogether(Fig.1 8).Justasthecoquinahasinterstitial porositysodoesthisglassfritmaterial,rangingfrom4%to14%byvolume.
1.2.5Stochastic,nonstochastic,andVoronoifoams Beforetheadventofadditivemanufacturing(AM)itwasvirtuallyimpossibletofabricate,inareproduciblemanner,theexactmicrostructureofachemicallyblownfoam. Studieswouldnormalizedatarelatedto foamsbasedondensitywiththeimplicit